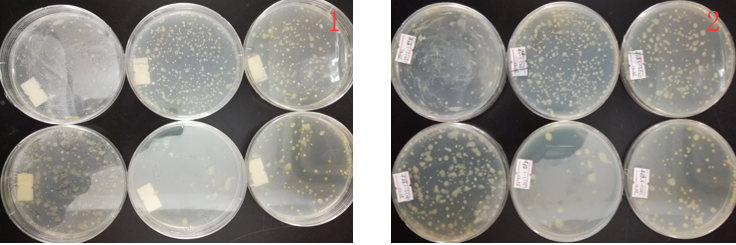
“超聲波處理對稻谷表面微生物的影響”發表論文啦！！

2017年12月與華南農業大學達成合作,委托華農大農學院的胡瓊波博士就“超聲波處理水稻谷種對病原菌的影響與研究”做項目指導。
12月27日由廣州金稻農業生產部長徐錦泉親自帶上超聲波處理機濕法、干法各1臺前往華農農業大學農學院處理谷種,谷種由胡博士提供。
本次實驗的使用的谷種是:象牙香占,分兩組對比,即干法、干種子對照各1個樣,濕法、凈水洗過的種子對照各1個樣,每份樣品100克,3次重復,共12個樣品。隨機取樣,樣品分裝。
使用的設備:由廣州市金稻農業科技有限公司提供的自主研發的植物種子增產處理機 型號5ZCS-50(濕法),自動上料植物種子干法處理機 型號5ZCG-50(干法)處理谷種。
左一:超聲波濕法處理(Twet)、左二和左三:常規凈水洗過的種子對照(CK1)
第一排:超聲波干法50速度處理(Tdy1)、第二排:超聲波干法25速度處理(Tdy2)、第三排:常規干種子對照(CK2)。
分別取稻谷1g于99ml 0.05%的吐溫-80的溶液中,搖勻,靜置15min,取0.1ml稀釋于99.9ml 0.05%吐溫-80溶液中。(摘要論文:1 .1實驗材料部分內容)
附錄A:種谷勻液培養結果展示 菌種形態,序列
附圖A.1 干法對照處理涂布法培養(1為培養皿正面,2為培養皿反面)

附圖A.2 濕法對照處理涂布法培養(1為培養皿正面,2為培養皿反面)
附圖A.3 超聲波濕法處理涂布法培養(1為培養皿正面,2為培養皿反面)
附圖A.4 超聲波干法處理(Tdy1)涂布法培養(1為培養皿正面,2為培養皿反面)
附圖A.5 超聲波干法處理(Tdy2)涂布法培養(1為培養皿正面,2為培養皿反面)
在通過平板涂布法檢查靜置取樣檢驗后,專家團隊得出結論:超聲波濕法處理(Twet)可以有效的減少細菌及真菌的菌落數量,超聲波干法處理(Tdy1、Tdy2)兩種均對稻谷表面的細菌殺菌力度并沒有這么強,更優于減少稻谷真菌的數量。
論文已在廣東農業科學第46卷第5期發表!!!
超聲波處理對稻谷表面微生物的影響
蔡 偉 1,嚴卓晟 2,William Jia Lan3,彭 彬 4,鐘堅文 2,張 杰 2,胡瓊波 1
(1. 華南農業大學農學院,廣東 廣州 510642;2. 廣州市金稻農業科技有限公司,廣東 廣州 510075;3. 上海交通大學法學院,上海 200240;4. 廣東省農業機械化技術推廣總站,廣東 廣州 510500)
摘 要:【目的】考察超聲波處理對種谷表面真菌與細菌的影響,比較不同處理方式的殺菌效果,分析
影響超聲波殺菌作用的因素以及超聲波促進稻谷萌發與壯秧的原因。【方法】以水稻品種象牙香占的種谷為材料,設 25~50 kHz 變頻超聲波濕法(Twet),50 kHz 超聲波干法(Tdry1)和 25 kHz 超聲波干法(Tdry2)3 個處理,以常規濕法(CK1)與干法(CK2)為對照,3 次重復。采用 PDA 平板涂布法分離種谷表面微生物,結合菌落形態及菌體顯微結構,以及 ITS 序列同源性分析,鑒定真菌與細菌。【結果】超聲波處理對種谷有殺菌作用,其中超聲波濕法處理(Twet)優于干法處理,而 50 kHz 超聲波干法處理(Tdry1)優于 25 kHz 超聲波干法處理(Tdry2)。檢測到的 15 種種谷表面細菌中,超聲波對甘蔗黃單胞菌 Xanthomonas sacchari、假單胞菌Pseudomonas aeruginosa、粘金黃桿菌 Chryseobacterium gleum、成團泛菌 Pantoea agglomerans、嗜麥芽窄食單胞菌Stenotrophomonas maltophilia 等豐度較低的細菌殺菌效果較好,但對陰溝腸桿菌 Enterobacter cloacae 和肺炎克雷伯菌 Klebsiella pneumoniae 等高豐度細菌殺菌效果較差。從稻谷表面檢測到 11 種真菌, 超聲波對層生鐮刀菌Fusarium proliferatum、尖孢鐮刀菌 F. oxysporum、串珠鐮刀菌 F. moniliforme,木賊鐮刀菌 F. equiseti 與莖點霉菌Phoma sp. 等殺菌效果較好,而對稻葉鞘腐敗病菌 Sarocladium oryzae 及草酸青霉菌 Penicillium oxalicum 等殺菌效果不顯著,可能是由于后者豐度太高所致殺菌效果偏低。【結論】超聲波處理對水稻種谷表面微生物具有殺菌作用,但其效果與超聲波處理方式、微生物種類及其豐度有關,超聲波濕法處理殺菌效果比干法處理更好,超聲波對低豐度的鐮孢菌類具有顯著殺菌效果,可能是促進水稻萌發與壯秧的原因之一。
關鍵詞:水稻;超聲波;細菌;真菌;殺菌
中圖分類號:S432.1 ? 文獻標志碼:A 文章編號:1004-874X(2019)
設備:自動上料植物種子干法增產處理機
型號:5ZCG-50
類別:干法

設備:植物種子增產處理機
型號:JD-50L
類別:濕法
增產+提質+抗逆性。良種+良法=新栽培技術!
聯系我們
廣州市金稻農業科技有限公司
張杰女士:13825098750
郵箱:13825098750@139.com
網址:http://m.cozylifeaustralia.com/
電話:020-61030702
美工記者:盧諾
從化種植基地:廣東省廣州市從化區鰲頭鎮鹿田村
廣州商務部:廣東省廣州市天河區燕嶺路燕橋大廈22樓2212室
南沙辦公室:廣東省廣州市南沙區東涌鎮市南公路663號(通用廠房6,7)自編【四】層【L4-10】號房
郵編:510935
